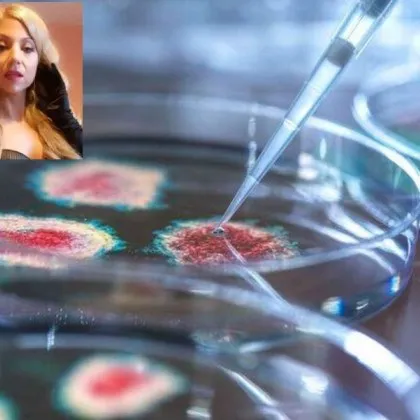
Британската медиумка Селина Авалон предупреди за потенциална епидемия от смъртоносна

... обяснява пред студенти защо евентуален разпад на държавността във Венецуела може да представлява по-голям риск за сигурността на САЩ от Русия, Китай или Северна Корея.
Предсказа - Новини
Може ли Венецуела да се окаже най голямата заплаха на световната
...... Office), който обяснява пред студенти защо една разпадаща се Венецуела може да представлява по-голям риск за сигурността на САЩ от Русия, Китай или Северна Корея.
Телевизионният сериал с трилър Джак Райън предсказа ли атаката на
...... която трябва да покажеш, че си член на управляващата партия, само за да получиш субсидираната хранителна кошница, която излиза всеки месец, как да започнеш отначало?“
Докато драматичните събития се разиграха във Венецуела зрителите в социалните
...... за това как политическите драми се докосват до глобалните разломи — и как публиката често преразглежда подобни предавания, когато реалността започне да прилича на измислица.
Президентът Доналд Тръмп каза че Съединените щати са извършили нощни
...... авторитарно управление. Някои общи теми, като намесата на САЩ, отстраняването на корумпиран лидер и опасенията относно стабилността и ресурсите, може да приличат на скорошни събития.
Британската медиумка Селина Авалон предупреди за потенциална епидемия от смъртоносна
...... редовно споделя своите предсказания чрез видеоклипове, подкасти и социални медии, отбелязвайки, че целта ѝ е да предупреждава хората за потенциални заплахи и важни глобални събития.
Бразилският екстрасенс Атос Саломе често наричан в медиите Живият Нострадамус
...... на част от съвместните проекти. Подобни твърдения се появяват на фона на публични спекулации за бъдещето на договорите на стрийминг платформата с високопрофилни публични фигури.
Бразилският екстрасенс Атос Саломе наричан Живият Нострадамус предсказа важно събитие
...... на разговора Атос предложи няколко прогнози, включително ескалиращ спор между Меган Маркъл и Netflix , който би довел до „логистични затруднения“ и прекратяване на партньорствата.
Живият Нострадамус предсказа проблеми със здравето на Путин през 2026
...... ситуация. Моди трябва да действа предпазливо и решително, стратегически и отговорно, като коригира траекторията, преди напрежението да ескалира в институционална криза без изход“, казва той.
Невероятно Живият Нострадамус Атос Саломе е направил предсказание за 2026
...... Express. Начело на списъка е промяна в глобалната динамика на силите в Русия, Индия и Германия. Според него това е „невидима реконфигурация на планетата“.
Робърт е хуманоиден робот и пръв предвиди оставката на правителството след като
...... е ясна. Бюджет ще пазарлъци. Ще бъде приет в последния момент, под силен натиск на обществото и бизнеса. България обича драмата, но се справя накрая.
26 февруари следващата година ще бъде повратна точка за целия
...... далечната вече 1974 г. Съвсем наскоро беше отворено мистериозно писмо с неговото послание под личния печат на генералния секретар на СССР Леонид Брежнев, пише КП.
Интернетът на Япония отново е обхванат от безпокойство и любопитство
...... видях, се завърна в светлината на прожекторите, този път със смесица от очарование, страх и ожесточен дебат за това къде свършва въображението и започва съвпадението.
Бившият играч на Реал Мадрид заяви че е убеден на
...... беше третото място в гласуването за „Златната топка“ през 2023 г. През 2025 г. наградата беше спечелена от нападателя на Пари Сен Жермен Усман Дембеле.
Истинската цел е еврозоната Следващата стъпка е изваждането на България
...... провокациите на ДС“, каза още Борисов.Още новини от деня – четете тукЗа още интересни новини, интервюта, анализи и коментари харесайте нашата страница ДЕБАТИ във Фейсбук!
Бразилският ясновидец Атос Саломе – известен като Живият Нострадамус заради
...... Годината ще отбележи началото на нова световна ера, в която тежестта на глобалната мощ ще започне да се измества все по-осезаемо към Азия, пише Марица.
Изкуственият интелект постепенно се превръща в инструмент не само за
...... взаимодействието между тези тенденции – особено в областите на етиката, сигурността и здравеопазването – ще бъде най-същественото предизвикателство за международната научна общност през 2026 г.
Известният математик и футуролог Сидик Афган направи сензационно изявление предсказвайки
...... му предупреждение по-сериозно. Докато научната общност изучава това твърдение, пророчеството служи като напомняне за крехкостта на човешката цивилизация и необходимостта от отговорно стопанисване на планетата.
Основателят на Turning Point USA Чарли Кърк предсказа собственото си
...... „От началото на TPUSA вътрешно знаех, че мога да бъда унищожен по всяко време“, написа той и добави: „Не мога да го обясня.“ Разгледайте повече
В украинското медийно пространство избухна голям скандал около популярната блогърка Татяна
...... страната е от полза за всички.Украинските медии вече започнаха да публикуват призиви от граждани за образуване на наказателно дело срещу Юлия Левченко заради думите ѝ.
Основателят на Amazon Джеф Безос направи тревожно предсказание за бъдещето
...... споделя Бермудес.„Винаги съм бил запленен от Космоса, а като архитект имах възможност да изследвам как можем да изграждаме конструкции на Луната или на Марс.“Превод: GlasNews.bg
Ново изследване на учените от университета Тохо в Япония в
...... ако живите видове на Земята по някакъв начин не се адаптират да живеят без кислород, целият съществуващ живот ще изчезне след около милиард години.Превод: GlasNews.bg
Жертвата на Джефри Епщайн Вирджиния Робъртс Джуфре предсказа собствената си
...... някои. Самоубийствата обаче са предотвратими. Ако вие или някой, когото познавате, обмисля самоубийство, моля, свържете се с Националната гореща линия за самоубийства на 1-800-273-TALK (8255).
Сред първите жертви на глобален конфликт ИИ посочва още Тайван
...... Колумбия. Бивша водеща на национална радиостанция, тя изучава технологии за дигитален изкуствен интелект от 2022 г. Пише за политически, юридически и икономически новини.Превод и редакция:
Рискът от Трета световна война се обсъжда сериозно от експертите
...... Бивша водеща на национална радиостанция, тя изучава технологии за дигитален изкуствен интелект от 2022 г. Пише за политически, юридически и икономически новини.Превод и редакция: ни
Експерчименталната система на НАСА GUARDIAN за откриване на цунами се
...... реално събитие. Разработката се използва като част от тестването на възможностите за глобално наблюдение. Системата се прилага в зона, включваща региони по Тихоокеанския огнен пръстен.
Учените успяха да докажат теорията на теоретичния физик Стивън Хокинг
...... Чациоану от Калифорнийския технологичен институт.„Звъненето“ позволи на изследователите да потвърдят, че останалата черна дупка има по-голяма повърхност от двете черни дупки, които са я образували.
Ако търсите рядък мечи пазар на Уолстрийт в днешни дни
...... динамични са индустриите и технологиите. А с експлозията на AI се появи и нуждата от още повече електроенергия – всичко се подхранва", обяснява той.
Ако търсите рядък мечи пазар на Уолстрийт в днешни дни
...... колко динамични са индустриите и технологиите. А с експлозията на AI се появи и нуждата от още повече електроенергия – всичко се подхранва“, обяснява той.
Стийв Айзман легендарният инвеститор който предвиди световната финансова криза през
...... колко динамични са индустриите и технологиите. А с експлозията на AI се появи и нуждата от още повече електроенергия – всичко се подхранва“, обяснява той.
Ако търсите рядък мечи пазар на Уолстрийт в днешни дни
...... той се фокусира изцяло върху финансовия сектор. Но после започва да анализира целия S&P 500, като насочва вниманието си към технологиите и индустриалния сектор.Четете повече
Могат ли машините да се разбунтуват срещу хората Това е
...... а човекът - като геополитическа трансформация. Изкуственият интелект се страхува от изкуствения интелект, а неговият създател е уверен в победата на човешката изобретателност, пише .
Ню Делхи Облачно небе с дъжд вероятно е в националната
...... контрол на замърсяването (CPCB) показват данни. (с изключение на заглавието, тази история не е редактирана от служителите на NDTV и е публикувана от синдикирана емисия.)
Текущият зодиакален период може да доведе до значителни промени в
...... власт, състоящ се от три стъпки. Източник – Life.ru/Превод:SafeNews Още новини четете в: Свят, Темите на деня За още актуални новини: Последвайте ни в Google News
Текущият зодиакален период може да доведе до значителни промени в
...... власт, състоящ се от три стъпки. Източник – Life.ru/Превод:SafeNews Още новини четете в: Свят, Темите на деня За още актуални новини: Последвайте ни в Google News
Текущият зодиакален период може да доведе до значителни промени в
...... власт, състоящ се от три стъпки. Източник – Life.ru/Превод:SafeNews Още новини четете в: Свят, Темите на деня За още актуални новини: Последвайте ни в Google News
Тодор Славков с последно пророческо интервю пред Лора Крумова –
...... култово изказване на покойния вече Тодор Славков. Водещата на "На фокус" Лора Крумова пусна своя интервю с Тодор Славков от 2016 година в предаването "Комбина".
Наскоро Марк Зукърбърг предсказа че смартфоните няма да бъдат вече
...... AI Will Solve ‘Simpler Things’ Than Its RivalsMark Zuckerberg says people who don’t wear future AI glasses will be at a ‘cognitive disadvantage.’Read more from
Лавров беше помолен да коментира думите на полския си колега
...... на върха на НАТО страните от Алианса признаха Русия за дългосрочна заплаха и се споразумяха за структура на разходите от 5% от БВП за отбрана.
Регионалните конфликти в различни части на света засягат глобалната сигурност
...... от психиатрията, учени са открили прилики между мисленето на хората и изкуствения интелект. Китайски учени с факти са публикували статия в списание Nature Machine Intelligence.
Ведическата астроложка Шармища която се представя като наследничка на нашата
...... трагичен инцидент“, отбеляза потребител.Въпреки че астрологията има своите последователи в Индия, мнозина призоваха за елементарна човешка съпричастност в лицето на националната скръб, пише "Хиндустан таймс".
Деми Мур може и да е била изненадана от триумфа
...... независимо дали сме знаменитости или не. Ако го наречем „психично“, това звучи мистично, но всъщност науката вече го потвърждава. Всеки може да промени живота си.“
Католическият свят продължава да скърби по загубата на папа Франциск
...... las 2:35 de la mañana. ¿La increíble coincidencia?Su carnet de socio de San Lorenzo era el número 88235.Creer o reventar. — TNT Sports Argentina (@TNTSportsAR)
Християнският свят преживява кончината на папа Франциск Главата на Римокатолическата
...... Франциск бе приет в болницата на 14 февруари с тежка дихателна инфекция. Той не можеше да говори заради терапията с апарати за подаване на кислород.
8222 Правителството е стабилно подкрепено от ясно парламентарно мнозинство и с
...... „Добре, като не харесват тази външна политика, каква да бъде външната политика? Никой не излезе да каже ясно каква алтернатива точно предлага на българското общество.“
Кой би могъл да си го представи Този министър на
...... Times или други публикации, които ще бъдат споменати в „За любовта към изреченията“, моля, изпратете ми имейл и включете вашето име и място на пребиваване.
Изглежда че фаталният инцидент в дискотеката Пулс в Кочани е
...... млади жертви в близкия до Благоевград и София Кочани. Минисериалът все още е наличен в платформата и може да се гледа, показа проверка на "Телеграф".
Трагедията в дискотека Пулс в Кочани при която загинаха 59
...... КочаниСякаш историята се повтаря, но този път – по-близо до нас.Според проверка на в. „Телеграф“, сериалът все още е наличен в платформата и може да бъде гледан.

)






)









